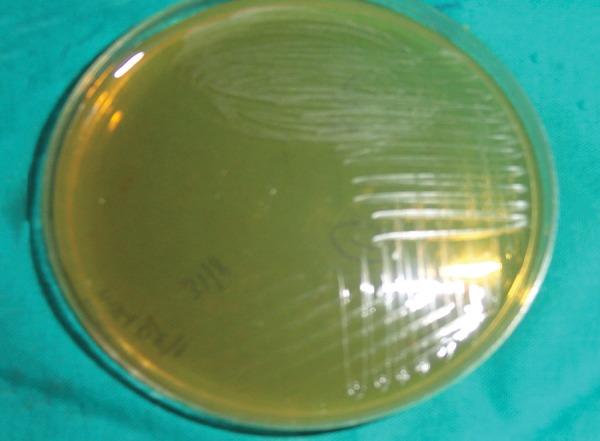
https://cdn.ncbi.nlm.nih.gov/pmc/blobs/a304/5360806/0915438b0d07/ijcpd-10-062-g003.jpg

氟化物涂剂对唾液中(某种物质)计数的影响 。 (原文中“Count”前缺少具体所指物质,翻译时根据语境进行了补充以使表达更完整)
Effects of Fluoride Varnish on Count in Saliva.
作者信息
Badjatia Sourabh, Badjatia Rini G, Thanveer K, Krishnan Ajith Cg
机构信息
Senior Lecturer, Department of Public Health Dentistry, Modern Dental College & Research Centre, Indore, Madhya Pradesh, India.
Senior Lecturer, Department of Pedodontics and Preventive Dentistry, Modern Dental College & Research Centre, Indore, Madhya Pradesh India.
出版信息
Int J Clin Pediatr Dent. 2017 Jan-Mar;10(1):62-66. doi: 10.5005/jp-journals-10005-1409. Epub 2017 Feb 27.
AIM
To evaluate the effect of fluoride varnish on count in saliva among 12-year-old school children.
MATERIALS AND METHODS
A field experiment was conducted to evaluate the effects of fluoride varnish on S. count in saliva among 12-year-old school children. A total of 42 school-going children attending schools in Vadodara district, Gujarat, India, were divided into two groups. Group I was treated with fluoride varnish and group II received no treatment. Assessment of S. was carried out at baseline and 3 to 6 months postfluoride varnish application. Friedman analysis of variance test and test were applied to detect statistically significant differences between baseline, 3 to 6 months of fluoride varnish application, and also between groups I and II.
RESULTS
The mean number of salivary S. value found in case group at baseline, 3 to 6 months was 31.23 ± 1.119, 9.27 ± 0.852, and 9.39 ± 0.908 × 10 colony-forming unit CFU/mL respectively. The difference in S. count from baseline to 3 to 6 months was highly statistically significant (p = 0.000), but the difference from 3 to 6 months was not statistically significant (p = 0.142). In control group, the mean value found at baseline, 3 to 6 months was 30.63 ± 1.436, 31.23 ± 1.351, and 31.40 ± 1.374 × 10 CFU/mL respectively. The differences between these values were not statistically significant (p = 0.11).
CONCLUSION
Statistically significant reduction in S. count in saliva was seen 3 to 6 months after fluoride varnish application.
HOW TO CITE THIS ARTICLE
Badjatia S, Badjatia RG, Thanveer K, Krishnan ACG. Effects of Fluoride Varnish on Count in Saliva. Int J Clin Pediatr Dent 2017;10(1):62-66.
目的
评估氟化物清漆对12岁学龄儿童唾液中(某种细菌,原文未明确写出)计数的影响。
材料与方法
进行一项现场实验,以评估氟化物清漆对12岁学龄儿童唾液中(同前)计数的影响。印度古吉拉特邦巴罗达地区的42名在校儿童被分为两组。第一组接受氟化物清漆治疗,第二组未接受治疗。在基线时以及应用氟化物清漆后3至6个月对(某种细菌,原文未明确写出)进行评估。应用弗里德曼方差分析检验和(原文未明确写出的某种检验)来检测基线、应用氟化物清漆3至6个月之间以及第一组和第二组之间的统计学显著差异。
结果
病例组在基线、3至6个月时唾液中(某种细菌,原文未明确写出)的平均计数分别为31.23±1.119、9.27±0.852和9.39±0.908×10菌落形成单位CFU/毫升。从基线到3至6个月(某种细菌,原文未明确写出)计数的差异具有高度统计学显著性(p = 0.000),但3至6个月之间的差异无统计学显著性(p = 0.142)。在对照组中,基线、3至6个月时的平均(某种细菌,原文未明确写出)值分别为30.63±1.436、31.23±1.351和31.40±1.374×10 CFU/毫升。这些值之间的差异无统计学显著性(p = 0.11)。
结论
应用氟化物清漆3至6个月后,唾液中(某种细菌,原文未明确写出)计数有统计学显著降低。
如何引用本文
Badjatia S, Badjatia RG, Thanveer K, Krishnan ACG.氟化物清漆对唾液中(某种细菌,原文未明确写出)计数的影响。《国际临床儿科学牙科杂志》2017;10(1):62 - 66。